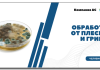
Как вывести плесень: Полное руководство

Содержание статьи:
Вы когда-нибудь задумывались о том, как можно вернуть молодость коже лица и тела? Сегодня мы поговорим об одном из самых эффективных методов омоложения — rf лифтинге лица и тела. Этот метод основан на использовании радиочастотной энергии для стимуляции выработки коллагена и эластина в коже, что приводит к ее подтяжке и омоложению.
Одним из главных преимуществ РФ лифтинга является его неинвазивность. В отличие от хирургических процедур, этот метод не требует разрезов или наркоза, что делает его более безопасным и комфортным для пациентов. Кроме того, процедура проводится быстро и безболезненно, что позволяет вернуться к обычной жизни сразу же после сеанса.
Но как выбрать правильную клинику для проведения процедуры? Важно обращать внимание на репутацию клиники и опыт врачей, которые будут проводить процедуру. Также стоит учитывать стоимость процедуры и гарантии результата.
Что такое РФ лифтинг и как он работает?
Так как же работает эта процедура или миостимуляция мышц тела? Во время сеанса РФ лифтинга используется специальный аппарат, который излучает радиочастотную энергию. Эта энергия проникает в глубокие слои кожи, стимулируя выработку коллагена и эластина — двух белков, ответственных за упругость и эластичность кожи.
Коллаген и эластин естественным образом разрушаются с возрастом, что приводит к появлению морщин и дряблости кожи. Однако, стимулируя выработку этих белков с помощью радиочастотной энергии, мы можем замедлить этот процесс и вернуть коже молодой вид.
Одним из главных преимуществ РФ лифтинга является то, что он может использоваться для омоложения не только лица, но и тела. Эта процедура может быть применена для лечения дряблости кожи на руках, животе, бедрах и других частях тела.
Также стоит отметить, что РФ лифтинг является малоинвазивной процедурой, что означает, что она не требует длительного периода восстановления. После сеанса вы можете сразу же вернуться к своей обычной деятельности.
Если вы заинтересованы в получении более подробной информации о процедуре РФ лифтинга, мы рекомендуем вам проконсультироваться со специалистом в области эстетической медицины. Они смогут предоставить вам более подробную информацию о процедуре и помочь вам определить, подходит ли она для ваших индивидуальных потребностей.

Преимущества и противопоказания процедуры
Преимущества:
- Улучшение внешнего вида кожи: лифтинг помогает избавиться от морщин, складок и дряблости кожи, делая ее более гладкой и упругой.
- Повышение самооценки: процедура может помочь вам почувствовать себя более уверенно и молодо.
- Длительный эффект: результат лифтинга сохраняется в течение длительного времени, что делает процедуру выгодной в долгосрочной перспективе.
Противопоказания:
- Беременность или кормление грудью: лифтинг не рекомендуется во время беременности или кормления грудью.
- Заболевания кожи: если у вас есть кожные заболевания, такие как экзема или псориаз, лифтинг может усугубить их.
- Заболевания крови: если у вас есть заболевания крови, такие как гемофилия, лифтинг может быть опасен.
Помните, что лифтинг — это серьезная процедура, которая требует тщательной подготовки и послеоперационного ухода. Обязательно проконсультируйтесь со своим врачом перед процедурой, чтобы убедиться, что она безопасна для вас.
Подготовка к процедуре и уход после нее
Также важно прекратить прием некоторых лекарственных препаратов, таких как аспирин и антикоагулянты, за несколько дней до процедуры. Обязательно проконсультируйся со своим врачом, если ты принимаешь какие-либо лекарства.
В день процедуры
Приходи на процедуру с чистой кожей. Не наноси никаких кремов или макияжа. Если процедура проводится на лице, лучше не есть за несколько часов до нее, чтобы предотвратить возможную тошноту или рвоту под действием анестезии.
После процедуры следуй инструкциям врача по уходу за кожей, как и при инъекции радиесс для лица. Обычно это включает в себя использование специальных кремов и гелей, которые помогут снять отек и ускорить заживление.
В течение нескольких дней после процедуры избегай физических нагрузок и воздействия солнца на обработанную область. Используй солнцезащитный крем с SPF не менее 30, если все же нужно выходить на улицу.
Уход в долгосрочной перспективе
После полного заживления кожи продолжай ухаживать за ней, используя качественные увлажняющие кремы и солнцезащитные средства. Регулярно проходи курс процедур, чтобы поддерживать результат лифтинга.
Не забывай о здоровом образе жизни. Здоровое питание, регулярные физические упражнения и достаточный сон помогут сохранить молодость и красоту кожи на долгие годы.